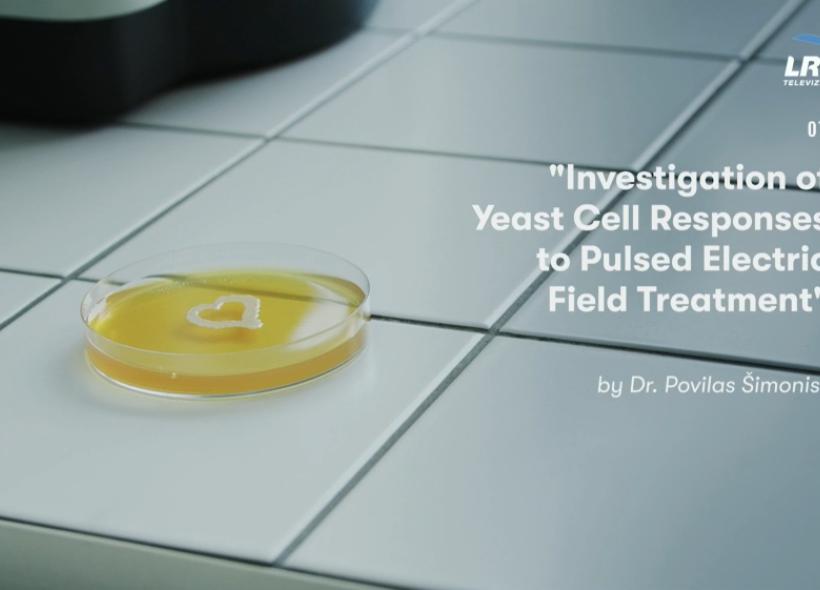

Naujienos
- Valstybinis mokslinių tyrimų institutas
Fizinių ir technologijos mokslų centras - Viešoji įstaiga
- Kodas 302496128
- PVM kodas LT100005300110
- Savanorių pr. 231, LT-02300 Vilnius
- +370 645 15550
- info@ftmc.lt
Sužinokite naujienas pirmieji
Mūsų svetainė naudoja slapukus (angl. cookies). Šie slapukai yra būtini, kad veiktų svetainė, ir negali būti išjungti.
Jei Jūs sutinkate, su slapukais, spauskite „Sutinku“ ir toliau naudokitės svetaine.
Kad veiktų užklausos forma, naudojame sistemą „Google ReCaptcha“, kuri padeda atskirti jus nuo interneto robotų, kurie siunčia brukalus (angl. spam) ir panašaus tipo informaciją.
Taigi, kad šios užklausos forma užtikrintai veiktų, jūs turite pažymėti „Sutinku su našumo slapukais“.
Jūs galite pasirinkti, kuriuos slapukus leidžiate naudoti.
Plačiau apie slapukų ir privatumo politiką.
| Pasirinkimas | Paaiškinimas |
|---|---|